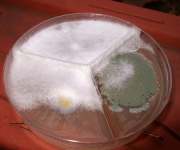
De Candida: Know the Facts

|
Starring on Dtheatre's Stage: Latest Movie News & Trailers, TV News and Productions,
Special Free Guides, Gadgets and Expert Reviews on Varity of Exciting Zones. We actually have a special expert responsible for every post series. Come back soon, you will always find new interesting things! |
![Digital Theatre [DTheatre.com]](../images/logo.png)

.jpg)
